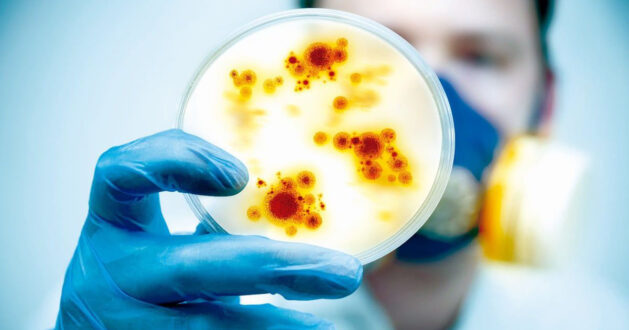

Bruselloz, dünyada ve ülkemizde çok yaygın olarak görülmesine rağmen hastalığın tanı ve tedavisini yönlendirmede kullanılabilecek kanıta dayalı bir rehber bulunmamaktadır. Bu rehber, brusellozun tanı ve tedavisi ile ilgilenen farklı uzmanlık alanlarından hekimlere kanıta dayalı öneriler sunmak üzere Türk Klinik Mikrobiyoloji ve İnfeksiyon Hastalıkları Derneği tarafından hazırlanmıştır.